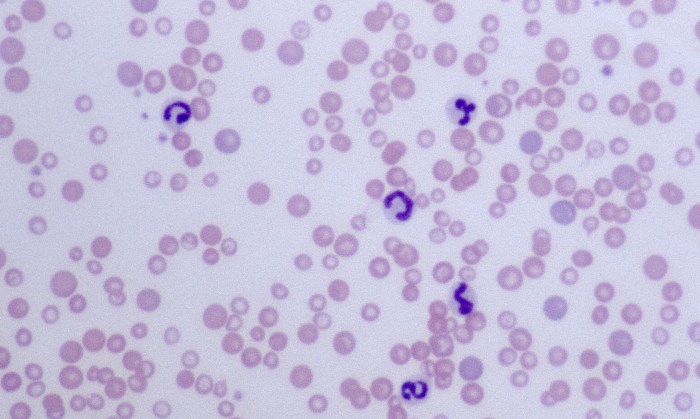
Microcytes 4 (Canine 4 - Iron Deficiency)

Microcytes

Morphology: red blood cells that are smaller than normal. May be hypochromic or normochromic. Central pallor is preserved (in dogs).
Look alike: spherocytes (may be difficult to distinguish spherocytes from microcytes in cats, horses, and cattle due to lack of central pallor in normal red blood cells).
Commonly seen with: other features of iron deficiency anemia (hypochromasia).
Clinical relevance: often associated with iron deficiency and portosystemic shunts. May be normal in young animals (puppies and kittens 4-8 weeks of age, calves and foals up to 1 year of age) due to physiologic iron deficiency. May also be normal in Japanese dog breeds (Akita, Shiba Inu). Microcytosis usually corresponds to decreased mean cell volume (MCV) on CBC.